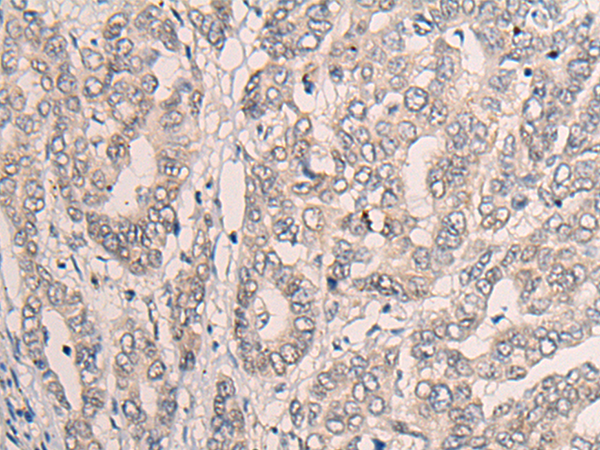
一抗

中文名稱:兔抗CLASP1多克隆抗體
|
Background: |
CLASPs, such as CLASP1, are nonmotor microtubule-associated proteins that interact with CLIPs (e.g., CLIP170; MIM 179838). CLASP1 is involved in the regulation of microtubule dynamics at the kinetochore and throughout the spindle (Maiato et al., 2003 [PubMed 12837247]). |
|
Applications: |
ELISA, IHC |
|
Name of antibody: |
CLASP1 |
|
Immunogen: |
Fusion protein of human CLASP1 |
|
Full name: |
cytoplasmic linker associated protein 1 |
|
Synonyms: |
MAST1 |
|
SwissProt: |
Q7Z460 |
|
ELISA Recommended dilution: |
5000-10000 |
|
IHC positive control: |
Human liver cancer |
|
IHC Recommend dilution: |
20-100 |

 購物車
購物車 幫助
幫助
 021-54845833/15800441009
021-54845833/15800441009